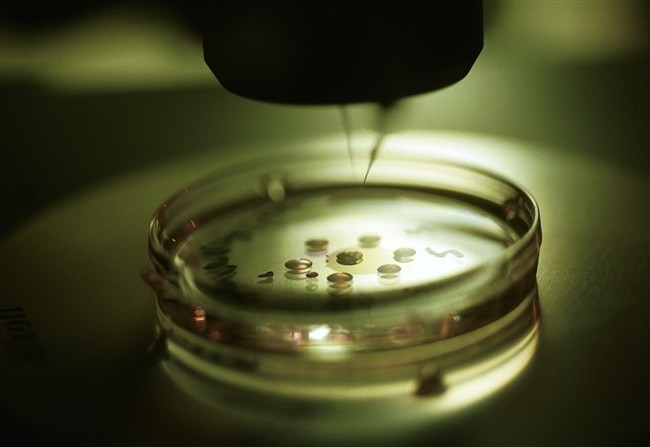

La Corte europea dei diritti umani di Strasburgo ha bocciato un articolo della legge italiana 40 sulla fecondazione assistita. La sentenza riguarda il ricorso di una coppia italiana fertile ma portatrice sana di fibrosi cistica contro il divieto di accedere alla diagnosi preimpianto degli embrioni. I sette magistrati hanno condannato lo Stato italiano a pagare 15mila euro per danni morali e 2.500 per le spese legali per la violazione del diritto al rispetto per la vita privata e familiare della coppia italiana.
APR news
Categorie:Politica
Lascia un commento